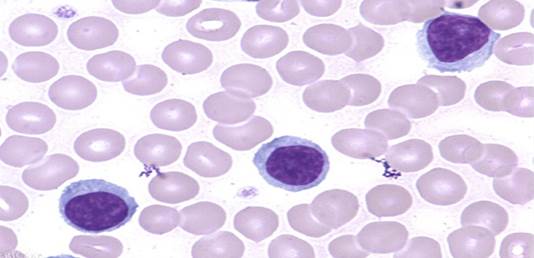
Picture background

Введение
По данным Всемирной Организации Здравоохранения, ежегодно в мире погибают из-за утопления 236 000 человек [1]. В зависимости от главенствующей в наступлении смерти роли патологии предложено подразделять утопление по патогенетическому типу на аспирационный, асфиктический [2]. Известно, что одной из важных систем, обеспечивающих местный гомеостаз органов дыхания в норме и патологии, является их эндокринный аппарат. При этом апудоциты ее вырабатывают гормоны и биогенные амины, в частности серотонин, обеспечивающий паракринную регуляцию в слизистой оболочке гортани (СОГ), в том числе спазм гладкомышечных волокон, содержащих рецепторы к этому биогенному амину [3; 4]. Наряду с этим количественная морфология реакций апудоцитов в СОГ при утоплении в зависимости от возраста животных не изучена; не представляется возможным наиболее точно проводить дифференциальную диагностику «сухих» (асфиктических) типов утопления [5, с. 259].
Цель исследования – разработка дополнительного микроскопического диагностического признака для верификации асфиктического типа утопления.
Материалы и методы исследования
Все эксперименты были проведены в соответствии с принципами, изложенными в Европейской конвенции по защите позвоночных животных, используемых в экспериментальных и других научных целях (Страсбург, 1986), а также Директивой 2010/63/EU Европейского парламента и Совета Европейского союза от 22 сентября 2010 года, касающейся защиты животных, применяемых в научных исследованиях. Проведение исследования было одобрено этическим комитетом ФГБОУ ВО «Южноуральский государственный медицинский университет» Минздрава России (Протокол № 23 от 22.09.2010г.).
Эксперимент был выполнен на 30 белых нелинейных крысах-самцах (из питомника и вивария Южно-Уральской государственной медицинской академии), которых, по методу аналогов, разделили на две группы: экспериментальную (ЭГ, n=20, возраст 2 мес., масса тела 220,15 ± 2,85 г) и контрольную (КГ, n = 10 крыс, возраст 6 мес., масса тела 490,0,9 ± 3,17 г). Содержание животных осуществлялось в условиях вивария с соблюдением основных зоогигиенических норм (температура 20-24 °С), при 12-часовом световом дне и свободном доступе к воде и корму.
У особей обеих групп производился забор крови в чистые сухие пробирки для получения сыворотки, в которой определялось содержание серотонина (пг/мл) методом иммуноферментного анализа [6]. Измерения проводились на программируемом фотометре для микропланшетов STAR FAX 303 PLUS (США) в соответствии с инструкциями производителя тест-систем (IBL, Германия).
Все животные ЭГ подвергались свободному плаванию в ванне (температура воды 26-28 °С) до утопления. Продолжительность плавания составила в среднем 5,82±0,72 минуты. После прекращения признаков жизни трупы животных извлекались из воды через 10 минут, осуществлялся забор периферической крови для определения уровня серотонина, проводилось вскрытие. Крысы КГ утоплению не подвергались.
Образцы гортани животных экспериментальной и контрольной групп фиксировались в жидкости Буэна, парафиновые срезы окрашивались гематоксилином и эозином, импрегнировались нитратом серебра по методу Гримелиуса; проводилась идентификация апудоцитов, содержащих серотонин, с использованием иммуногистохимического метода окрашивания срезов: краситель DAB, первичные специфические для крыс антитела к серотонину АВ-1 в разведении 1:100 (Sigma, клон 5 НТ-Н 209, США), вторичные антитела, меченные пероксидазой, с последующим докрашиванием гематоксилином.
Препараты изучались под световым микроскопом (Leiсa, Германия) с применением компьютерной программы анализа изображений ImageScope M (Россия). Подсчитывалось количество аргирофильных и серотонинсодержащих апудоцитов на 1 мм² площади среза слизистой оболочки гортани. Фотосъемка осуществлялась с использованием фотокамеры (Leiсa, Германия) при увеличении х400, х600.
Статистическая обработка данных проводилась с помощью программ Statistica 6.0: методы вариационной статистики, U-критерий Манна - Уитни (М ± m, при р < 0,05).
Результаты исследования и их обсуждение
Исследование содержания серотонина в сыворотке крови показало, что уровень его у крыс ЭГ до утопления был статистически значимо ниже, чем у крыс КГ. Однако после утопления уровень серотонина у животных ЭГ был значительно выше по сравнению с КГ (табл. 1).
Таблица 1
Содержание серотонина в сыворотке крови крыс ЭГ и КГ (пг/мл; М±m)
|
Показатель |
ЭГ (n=20) |
КГ (n=10) |
|
|
До утопления После утопления |
35,7 ± 2,08* 45,9 ± 2,85** |
40,8 ± 3,17
|
|
Примечание: * р < 0,05 по отношению к КГ; **р <0,05 по сравнению с показателем у крыс до утопления.
Источник: составлено авторами на основе [7].
При проведении аутопсии животных из ЭГ были выявлены следующие характерные признаки: острая эмфизема легких, петехиальные кровоизлияния под плеврой (рис. 1-3).

Рис. 1. Центрилобулярная эмфизема легкого (макропрепарат)
Источник: составлено авторами на основе [7].

Рис. 2. Эмфизема легкого. Окраска гематоксилином и эозином, х100
Источник: составлено авторами на основе [7].

Рис. 3. Субплевральное кровоизлияние, эмфизема легкого.
Окраска гематоксилином и эозином, х100
Источник: составлено авторами на основе [7].
Наряду с этим отмечалась воздушная эмболия сосудов легких, лимфогемия грудного лимфатического протока (рис. 4, 5).

Рис. 4. Воздушная эмболия: пузырьки воздуха в вене легкого.
Окраска гематоксилином и эозином, х400
Источник: составлено авторами на основе [7].
Рис. 5. Лимфогемия: эритроциты в грудном лимфатическом протоке.
Окраска по Романовскому-Гимзе, х900
Источник: составлено авторами на основе [7].
При гистологическом исследовании препаратов, окрашенных по методу Гримелиуса, с использованием иммуногистохимической реакции, в СОГ и железах обнаружены апудоциты различной формы (округлой, трапециевидной, треугольной и овальной) и окраски (от светлого до темно-коричневого цвета) (рис. 6, 7).

Рис. 6. Аргирофильные гранулы в апудоцитах СОГ.
Гистохимическая окраска по Гримелиусу, х400
Источник: составлено авторами на основе [7].

Рис. 7. Серотонинсодержащие апудоциты в СОГ. Иммуногистохимическая реакция, х600
Источник: составлено авторами на основе [7].
Морфометрический анализ показал, что в экспериментальной группе количество АПУД-клеток и серотонинпродуцирующих апудоцитов значительно превышало аналогичные показатели в контрольной группе (табл. 2).
Таблица 2
Содержание аргирофильных и серотонинпродуцирующих апудоцитов в СОГ крыс в зависимости от группы наблюдения (М±m)
|
Показатель |
Группа наблюдения |
|
|
ЭГ (n=20) |
КГ (n=10) |
|
|
Аргирофильные апудоциты, n/мм² |
26,91 ± 2,84* |
12,82 ± 3,16 |
|
Серотонинпродуцирующие апудоциты, n/мм² |
18,53 ± 2,07* |
10,31 ± 2,22 |
Примечание: *р < 0,05 по отношению к КГ.
Источник: составлено авторами на основе [7].
Возможно, что физическое переутомление (длительное плавание) адаптирует организм животных к стрессу [6]. Это приводит, по данным собственного исследования, к развитию острой аноксии, способствующей повышению уровня серотонина в крови и гиперплазии серотонинпродуцирующих апудоцитов в мышцах гортани, что сопровождается развитием ларингоспазма и утопления по асфиктическому типу. Кроме того, известно что в легких здорового человека количество аргирофильных и серототонинсодержащих апудоцитов существенно больше у плодов и новорожденных детей, меньше - у взрослых; их соотношение составляет 4 : 1 [3]. Показано, что при различных патогенетических типах утопления и острых пневмониях у детей, сопровождающихся развитием гипоксии, число аргирофильных и серотонинпродуцирующих апудоцитов значительно увеличивается [7; 8], что согласуется с результатами собственного исследования.
Данные литературы свидетельствуют, что особенности патогенеза асфиктического типа утопления до конца не изучены. Считается, что фактором, определяющим наступление смерти при данном типе утопления, является развитие рефлекторного ларингоспазма в связи с попаданием воды в носоглотку и гортань [4; 9; 10, с. 258]. Наряду с этим тонкие механизмы развития ларингоспазма на клеточном уровне с участием АПУД-системы воздухоносных путей практически не изучены. В связи с этим выявленное с помощью иммуногистохимического и морфометрического анализа значительное увеличение содержания серотонинпродуцирующих апудоцитов в слизистой оболочке гортани может являться, наряду с другими морфологическими проявлениями (эмфизема легких, воздушная эмболия левых отделов сердца, мелкоточечные субплевральные кровоизлияния [11, c. 168; 12, c. 282; 13]), одним из дополнительных диагностических признаков асфиктического типа утопления [7]. Результаты исследования подтверждают известную аксиому о том, что не может быть нарушения функции без нарушения структуры и «даже ничтожнейшие функциональные изменения не могут возникнуть и исчезнуть, не отразившись в соответствующих структурных изменениях на молекулярном или ультраструктурном уровне» [14, с. 327].
Заключение
Таким образом, при иммуногистохимическом и морфометрическом исследовании АПУД-клеток в СОГ у животных 2-месячного возраста выявлено значительное увеличение количества серотонинпродуцирующих апудоцитов по отношению к аналогичному показателю крыс КГ и 6-месячного возраста. Это способствует развитию ларингоспазма без проникновения воды в воздухоносные пути и легкие при асфиктическом типе утопления. В то же время наличие феномена выраженной гиперплазии серотонинпродуцирующих апудоцитов в СОГ в условиях острой аноксии у более молодых животных может быть использовано в качестве одного из дополнительных микроскопических диагностических методов диагностики асфиктического типа утопления при экспериментальных исследованиях, а также для его апробации в судебно-медицинской практике.
Библиографическая ссылка
Гиниатуллин Р.У. МОРФОЛОГИЧЕСКИЕ АСПЕКТЫ ДИАГНОСТИКИ АСФИКТИЧЕСКОГО ТИПА УТОПЛЕНИЯ (ЭКСПЕРИМЕНТАЛЬНОЕ ИССЛЕДОВАНИЕ) // Современные проблемы науки и образования. 2025. № 5. ;URL: https://science-education.ru/en/article/view?id=34293 (дата обращения: 15.04.2026).
DOI: https://doi.org/10.17513/spno.34293



